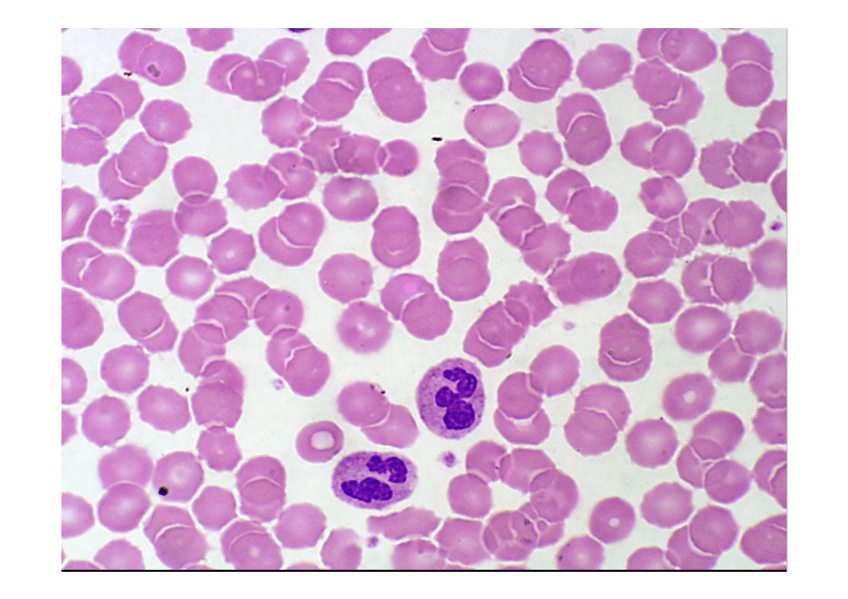

@AlejandraUD
49 Publicaciones
4.45k Interacciones
0 Seguidores
1 Siguiendo
Lista de publicaciones de AlejandraUD
apuntes
-
ALTERACIONES SERIE ROJA
He publicado nuevos apuntes de 2º Patología General: Semiología y Propedéutica: ALTERACIONES SERIE ROJA
He publicado nuevos apuntes de 1º Histología Humana: TEMA 41- VÍAS RESPIRATORIAS.pdf
Seminario con las láminas comentadas de las corregidas en clase
apuntes
-
Seminarios Histología
He publicado nuevos apuntes de 1º Histología Humana: Seminarios Histología
He publicado nuevos apuntes de 1º Histología Humana: TEMAS 11-13 - TEJIDO SANGUÍNEO.pdf
He publicado nuevos apuntes de 1º Histología Humana: TEMAS 8-10 - TEJIDO ÓSEO .pdf
He publicado nuevos apuntes de 1º Histología Humana: TEMA 25 Y 26 - SISTEMA INMUNITARIO.pdf
He publicado nuevos apuntes de 1º Histología Humana: TEMAS 14 - 16 TEJIDO MUSCULAR.pdf
He publicado nuevos apuntes de 1º Histología Humana: TEMAS 17-20 TEJIDO NERVIOSO .pdf
He publicado nuevos apuntes de 1º Histología Humana: TEMA 21-24- SISTEMAS VASCULARES SANGUÍNEOS Y LINFÁTICO.pdf
He publicado nuevos practicas de 1º Histología Humana: PRÁCTICA I HISTOLÓGICO.pdf
He publicado nuevos apuntes de 1º Histología Humana: TEMA 7 - TEJIDO CONJUNTIVO ESQUELÉTICO.pdf
He publicado nuevos apuntes de 1º Histología Humana: TEMA 5 - CLASIFICACIÓN Y VARIEDADES DEL TEJIDO CONJUNTIVO. .pdf
He publicado nuevos apuntes de 1º Bioquímica y Biología Molecular Básica: TRADUCCIÓN TEXTO DE LA ISQUEMIA-REPERFUSIÓN.pdf
Traducción del texto "You Down With ETC? Yeah, You Know D!" en el que he obviado algunas cosas, resumiendo al máximo.
otros
-
Láminas Mudas
He publicado nuevos otros de 1º Anatomía Humana General: Láminas Mudas